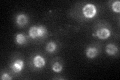
YMR153W
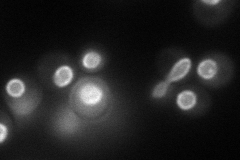
YMR153W
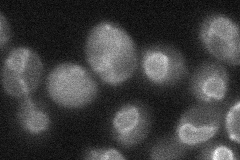
YMR153W
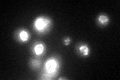
YMR153W
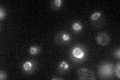
YMR153W

View description
Subunit of the nuclear pore complex (NPC), interacts with karyopherin Kap121p or with Nup170p via overlapping regions of Nup53p, involved in activation of the spindle checkpoint mediated by the Mad1p-Mad2p complex
Localization:
Intensity:
Fold change:
Significance:
-
C’ GFP library in SD
nuclear periphery37.09 -
N' NOP1pr-GFP in SD
nuclear periphery78.0883 -
N' TEF2pr-mCherry in SD

vacuole membrane63.3376 -
N' NATIVEpr-GFP in SD

punctate,nuclear periphery23.8785 -
N' TEF2pr-VC and Cyto-VN in SD
nuclear periphery37.2037 -
C’ GFP library in SD+DTT
nuclear periphery37.251No -
C’ GFP library in SD+H2O2

nuclear periphery27.490.74No -
C’ GFP library in Starvation Media
nuclear periphery42.641.14No -
C’ GFP library on the background of Pup2-DaMP

N/A -
C’ GFP library on the background of CCT mutant

N/A0N/AYes
